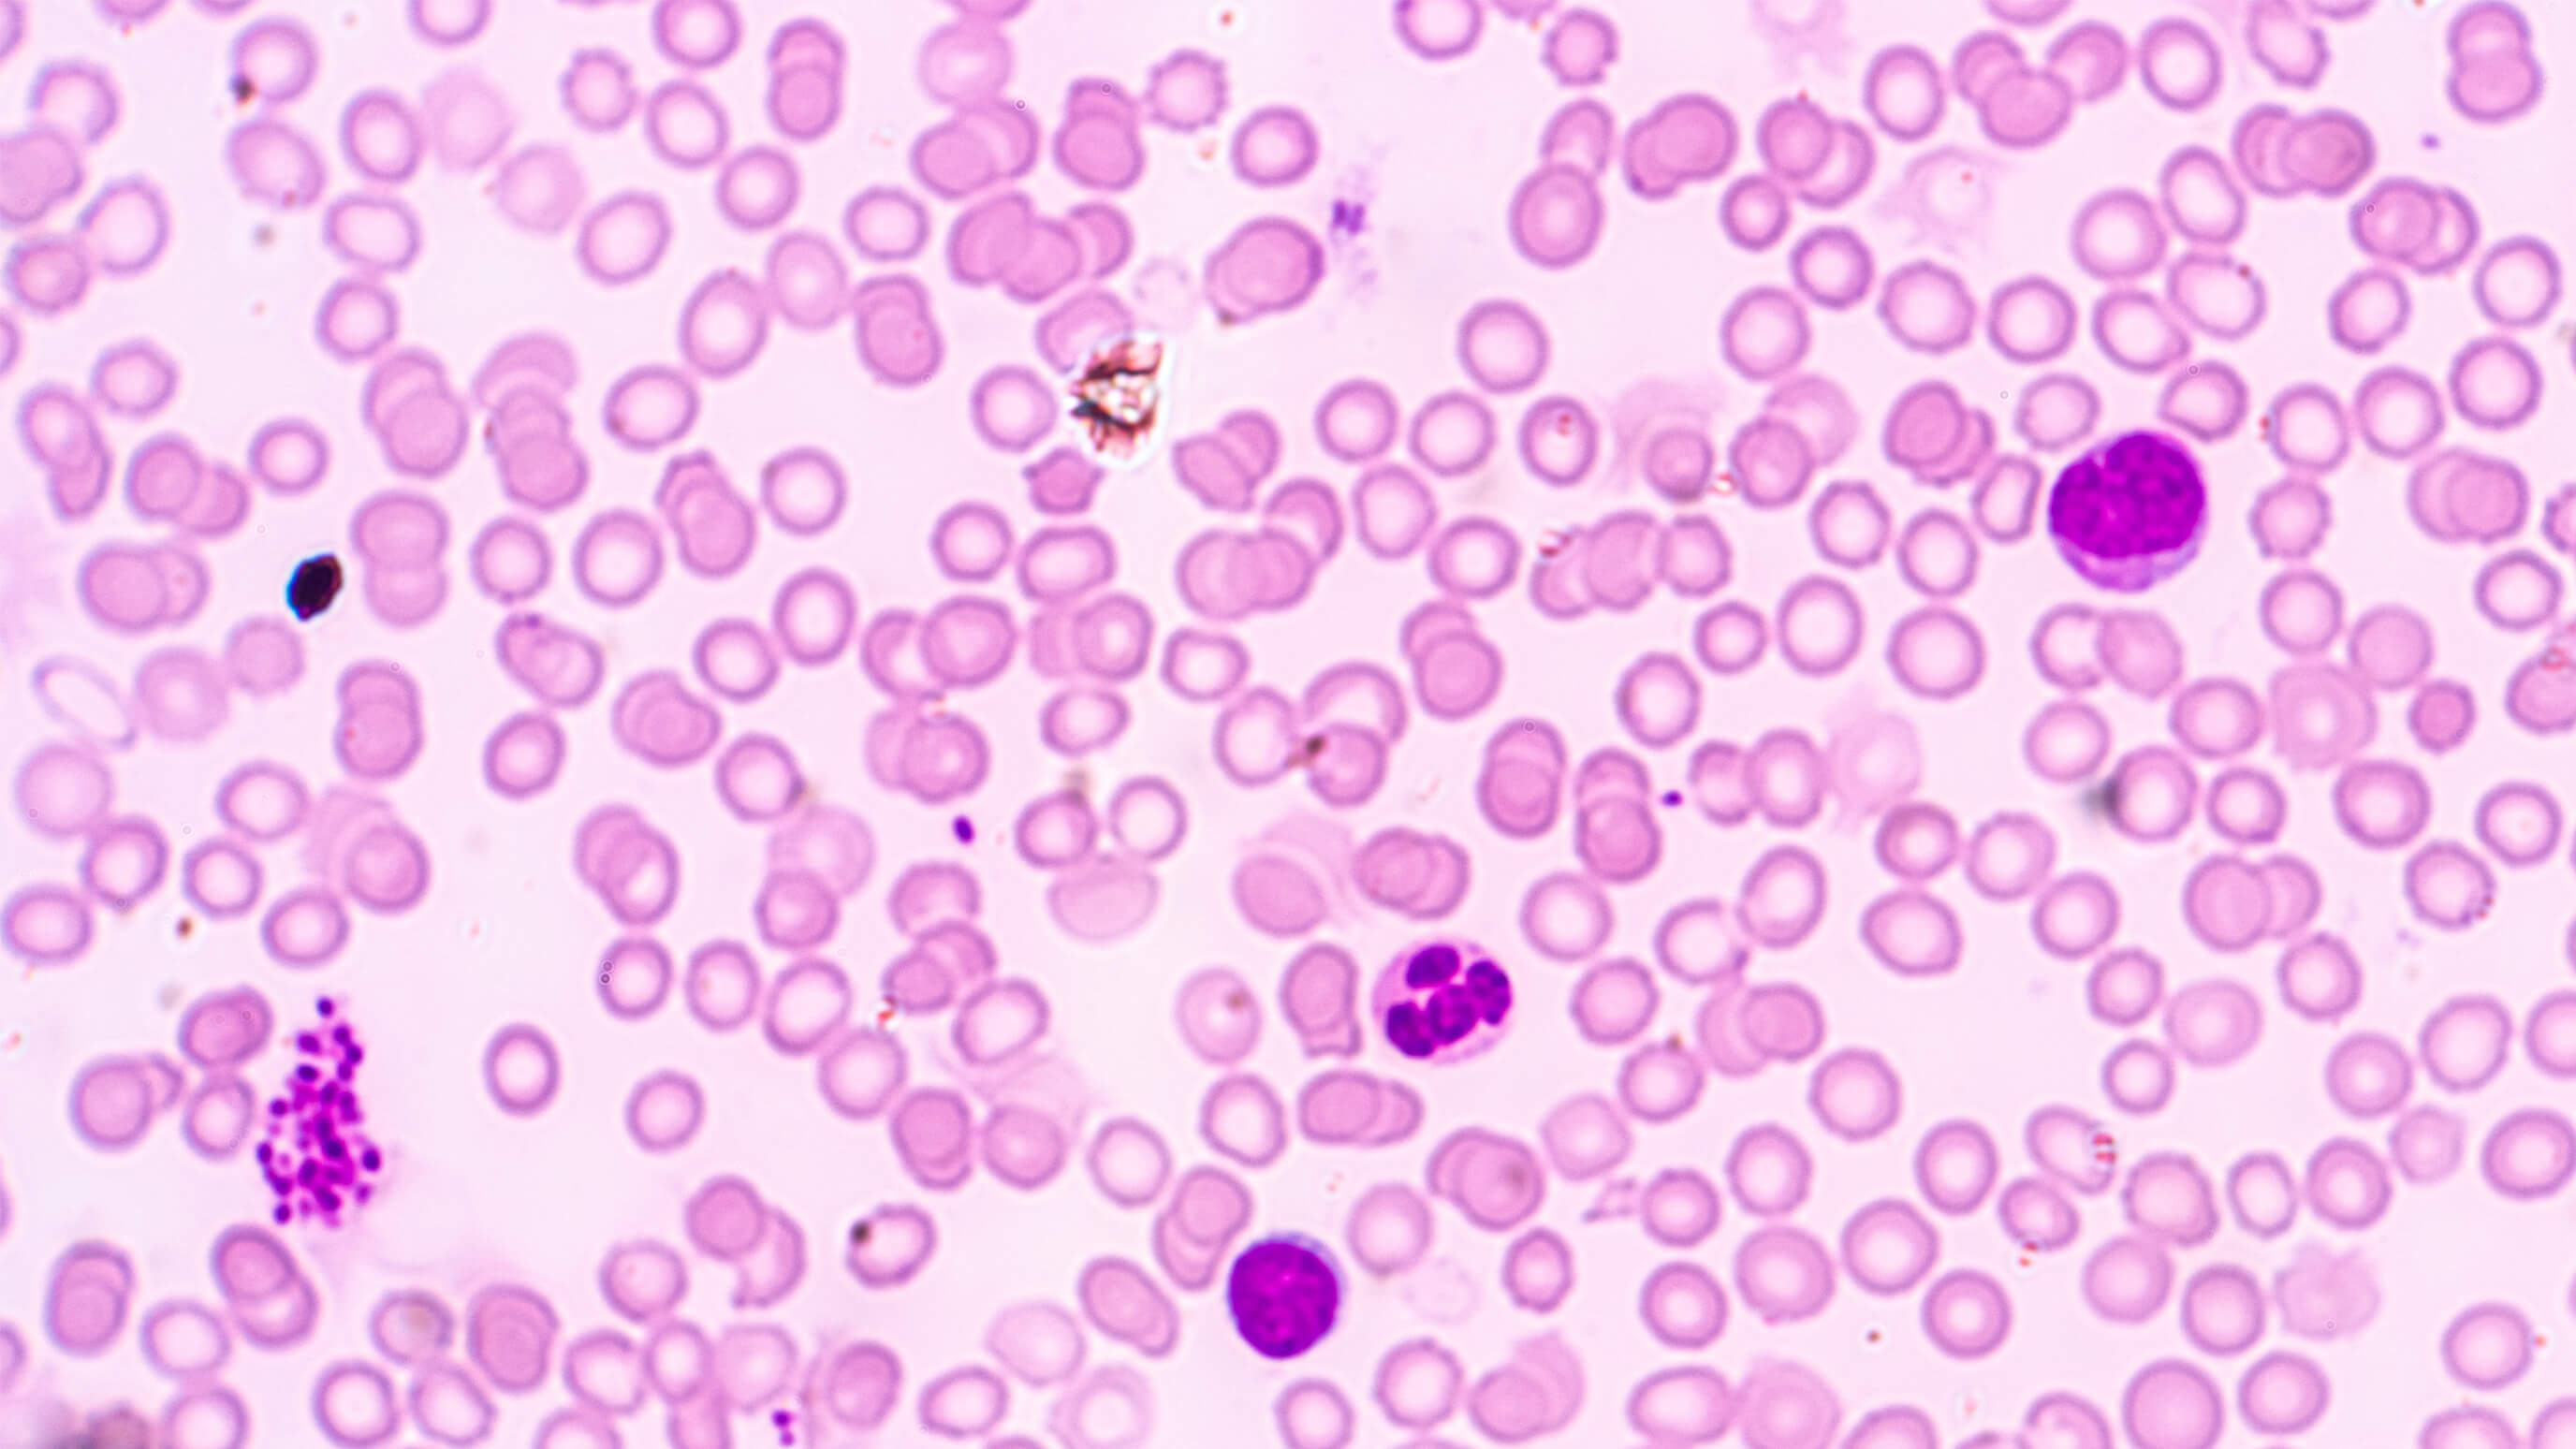

Combining Our Strengths
As part of AstraZeneca, we are working to expand access to our portfolio of medicines to improve outcomes for more people living with rare haematological diseases worldwide.

Working to improve potential outcomes for more people living with rare haematological diseases worldwide.
For more than two decades, our innovations in rare disease medicines have positively transformed the trajectory of the patient journey for people living with certain rare haematological diseases-establishing and advancing the treatment landscape for a rare, chronic, progressive and potentially life-threatening blood disease driven by dysregulation of the complement system.
We are committed to following the science, improving the understanding of rare haematological diseases and enhancing the patient and caregiver journey.
As part of AstraZeneca, we are working to expand access to our portfolio of medicines to improve outcomes for more people living with rare haematological diseases worldwide.

Researching and developing innovative treatments that aim to target the underlying causes of rare bone disorders.

Following the science to develop and evaluate potential innovative treatment options to help people living with rare cardiology conditions.

Identifying potential new opportunities to advance care for those impacted by rare endocrine diseases.

Enhancing the understanding of rare renal diseases and accelerating the development of potential therapies.

Striving to advance scientific understanding in rare neurology and to accelerate the development of potential life-changing treatments.

Striving to advance scientific understanding of rare cancers to bring new solutions.
Veeva ID: GL/ALL/0030